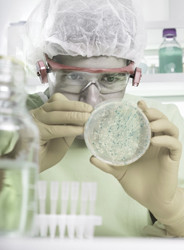

Sonda biologica per i microbi
Il progetto MICROBIALSPM ("Microbial recognition and adhesion on the nano scale using BIO-SPM"), finanziato dall'UE, ha studiato a fondo l'interazione tra Escherichia coli (E. coli) vivo, e il suo ambiente biotico (vivo) e abiotico (senza vita). La microscopia a scansione di sonda (SPM) ha reso in visualizzazione nanoscalare le modifiche fisiche e biochimiche subite da E. coli. Le tecniche di SPM includevano spettrometria a forza, topografia e imaging di riconoscimento, microscopia a forza di sonda kelvin (KPFM) e microscopia a scansione a microonde. Le punte per SPM erano caricate con molecole biologicamente attive per migliorare la specificità di risoluzione a livello nanometrico e di pico-Newton. I ricercatori hanno studiato le modifiche nel batterio e nelle sue strutture di superficie quando viene in contatto con, e quando colonizza, superfici biotiche e abiotiche in diverse condizioni ambientali. In diverse condizioni di crescita colturale, le variazioni nella morfologia e nella funzione batterica sono state studiate nella distribuzione delle cariche di superficie, utilizzando tecniche come KPFM e SMM. Gli scienziati hanno mappato le proprietà chimiche e meccaniche di superficie. I ricercatori sono così riusciti a chiarire i meccanismi sottesi e le interazioni biomolecolari coinvolte in queste interazioni. Le tecnologie SMP sviluppate durante questo progetto forniscono una risoluzione e sensibilità senza precedenti per la visualizzazione di cellule o sistemi vivi in condizioni dinamiche. Metodi di rilevamento elettrico nanoscalari di questo tipo per sistemi biologici potrebbero essere sfruttati per sviluppare biosensori e dispositivi diagnostici miniaturizzati. Le attività del progetto hanno inoltre posto le basi per studi futuri sulla patogenesi delle malattie e l'efficacia dei farmaci. Ciò ha implicazioni importanti per la scienza dei materiali, la chimica delle superfici, le industrie biotech e farmaceutica.